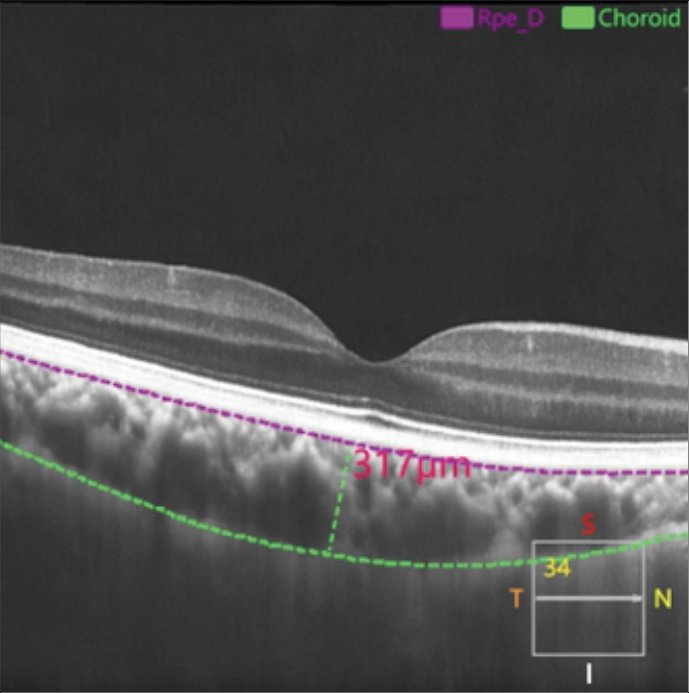
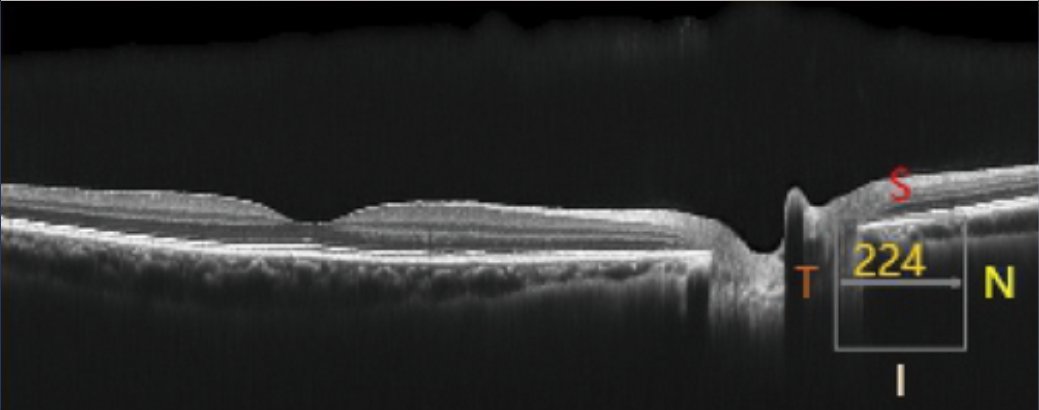
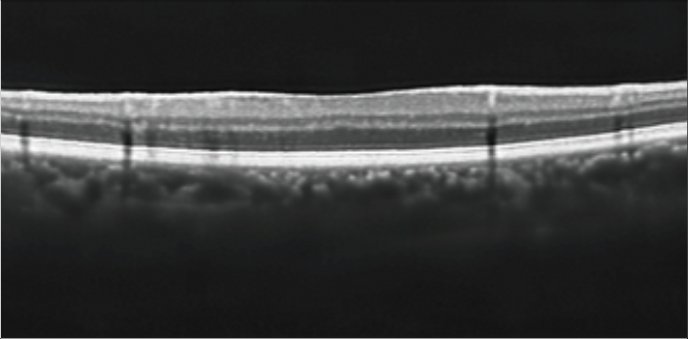
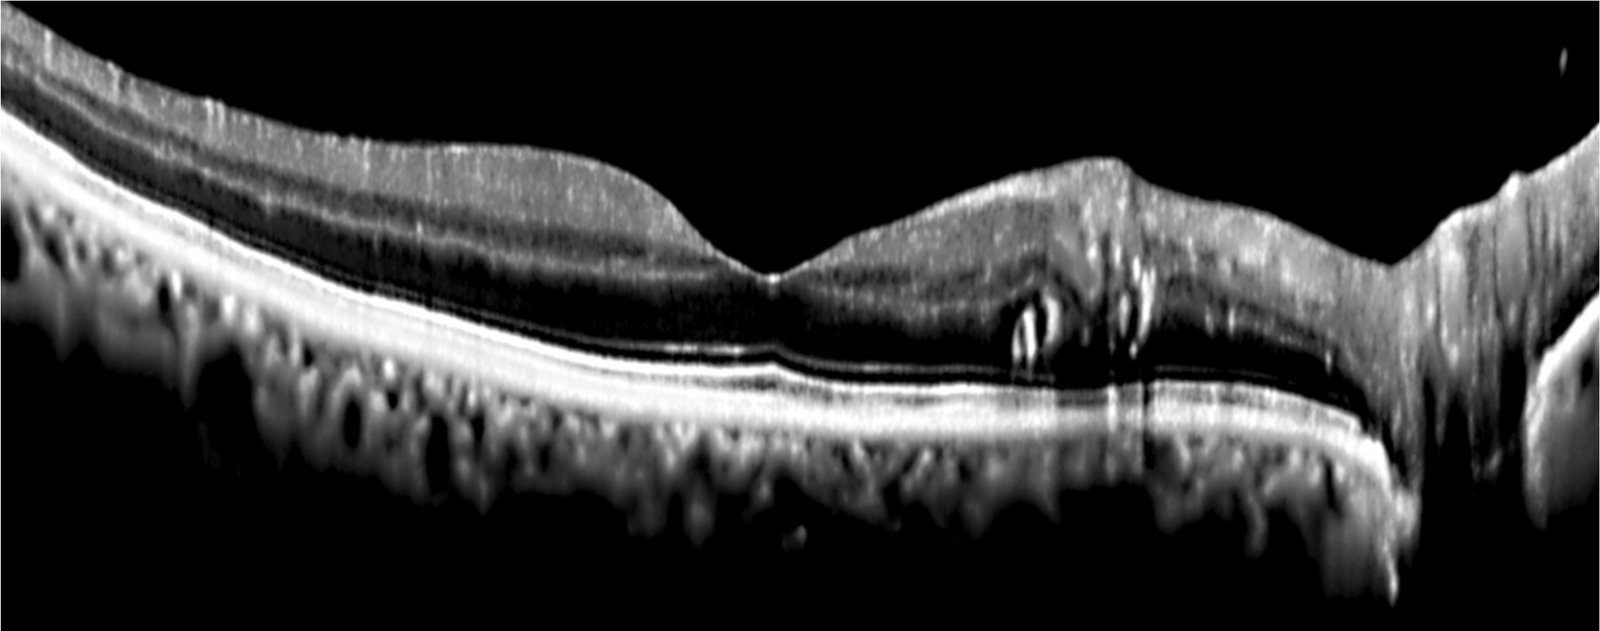
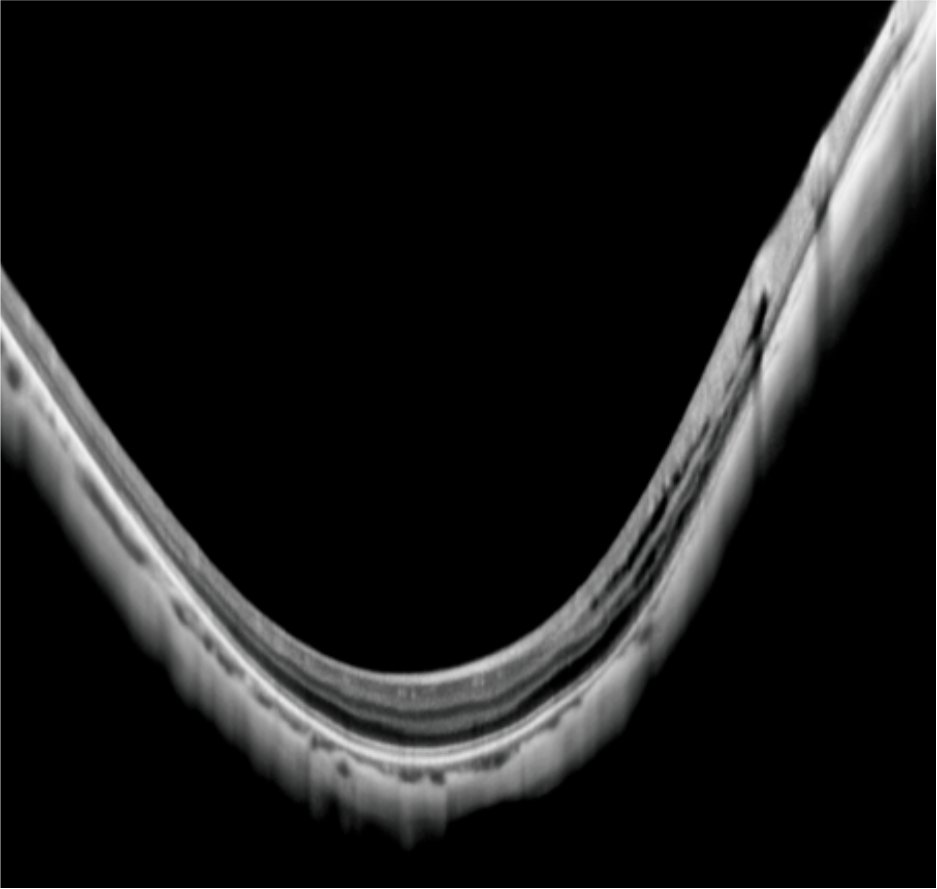
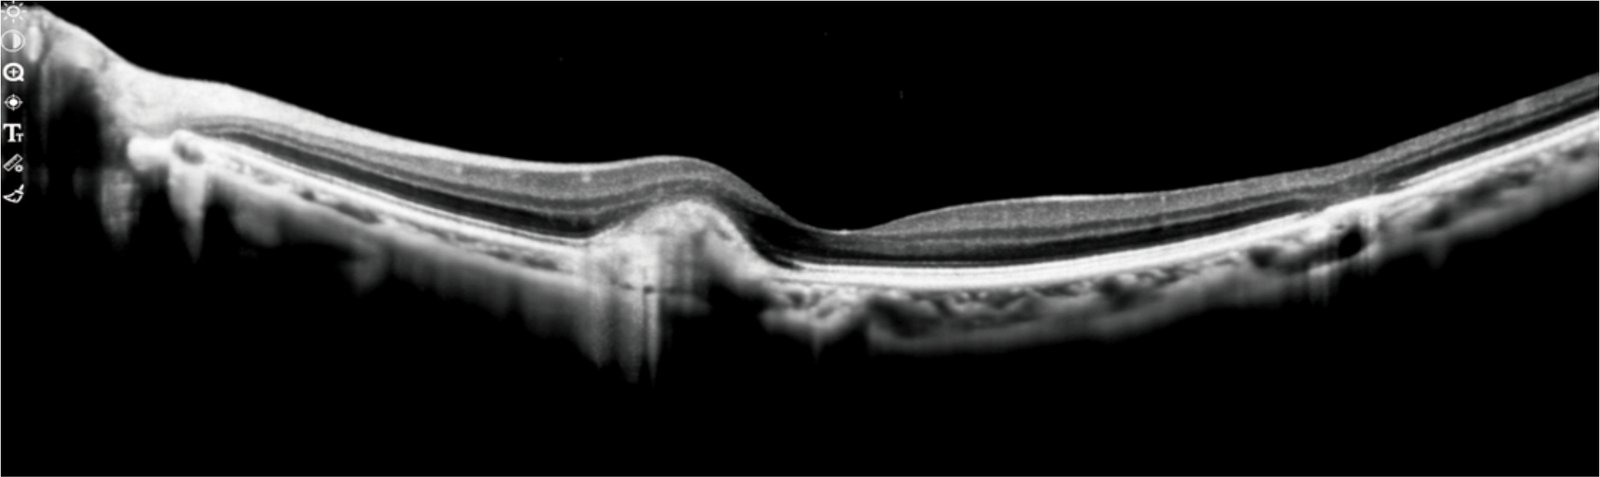
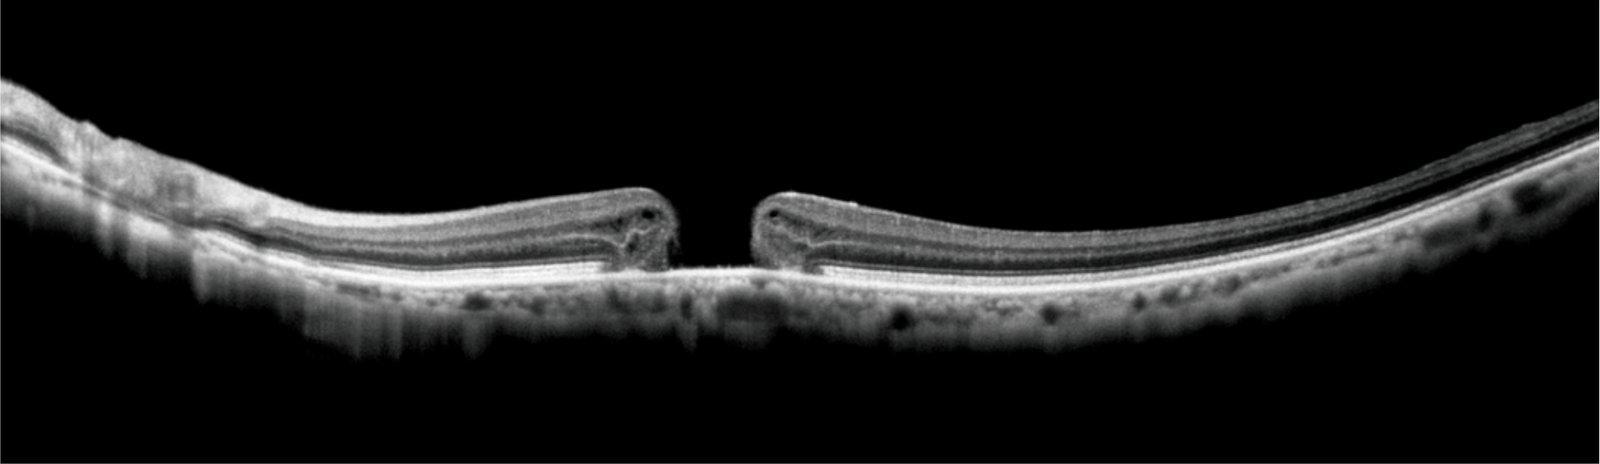
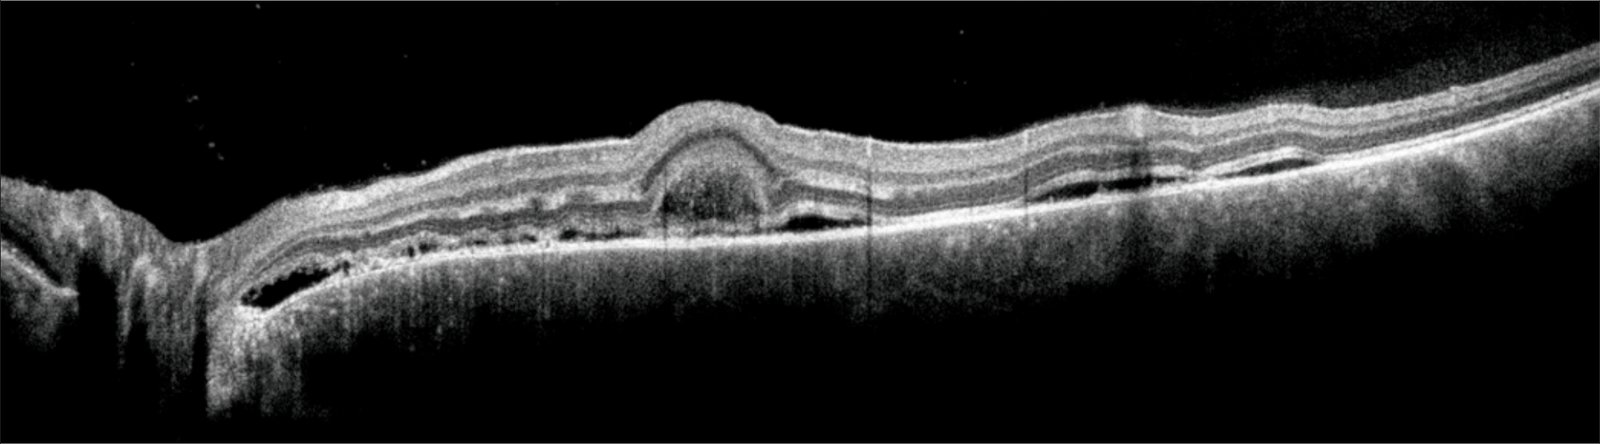
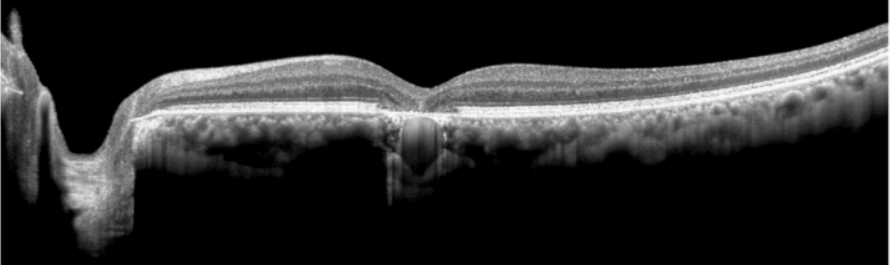

EOCT 1 Artifical Intelligence OCT
Artificial Intelligence in Optical Coherence Tomography (AI-OCT) enhances retinal imaging by using machine learning to analyze OCT scans quickly and accurately. AI automates the detection of eye diseases like glaucoma, diabetic retinopathy, and macular degeneration, improving diagnosis, treatment monitoring, and early detection. This technology enables faster, more precise analysis, reducing human error and helping clinicians make informed decisions.
Product leading Al screening technology Empowering eye CT detection
Scenarios of Application
Eye optometry center
Physical Examination Center
Hospital, Community Clinic
Subject of Application
Myopia prevention and control
Screening for Diabetic Retinopathy
Screening of eye diseases for the elderly
1) High speed scanning, Ultra high definition imaging
86000 times/s, monocular scan in 2 seconds, high-definition tomography imaging, clear stratification facilitates diagnosis
2) Automatic stratification measurement for choroid membrane
Accurate detection for myopia development intervention
3) Comprehensive functions, to meet a variety of needs
OCT functions such as fundus imaging, anterior segment imaging, SLO fundus imaging, eye tracking, and imaging of cloudy liquids are equipped
4) Al eye disease screening system, to locate the abnormal images
Automatically identify common fundus lesions and conduct risk assessment
5) Cloud data archiving for information linkage
Cloud data aggregation with multiple terminals, efficient information linkage, instant transmission and reading, and high-speed information exchange
Al diagnosis, one-click enabling optometry detection / eye disease screening
Eyevis OCT provides artificial intelligence disease screening systems.The systems can facilitate rapid fundus screening at the basic optometry center and improve diagnostic efficiency and accuracy. The systems can issue the diagnosis report with one button, with the accuracy of up to 97%. The systems are suitable for primary healthcare and optometry industries. At the same time, the Al Diagnosis Cloud Platform is built to realize data linkage
Data Source: From over 10,000 People real scene test
AI Analysis Report
8K/4K Full HD
Resolution is 5µm
Artificial Intelligence Diagnosis
Eye Tracking
| Feature | Specification |
|---|---|
| Scanning speed | ≥86000 A-Scan/S |
| Image quality | SD; HD; 8K/4K |
| SLO function | Yes |
| Eye tracking function | Yes |
Automatic stratification measurement of choroid membrane (Myopia developmental intervention precision testing)
Automatic thickness measurement, no manual layering required
OCT functions include multiple scanning modes such as line scanning, grid scanning, and three-dimensional scanning, Macular fovea choroidal thickness (SFCT), choroidal subarachnoid thickness map and mean choroidal thickness in the macular region can be measured.
Thickness monitoring before and after myopia prevention and control



Report of high myopia choroid
Autofocus, less inspection time and easier operation
Al layering, automatic calculation of choroidal thickness
Automatic presentation of choroidal thickness and distribution map

Glaucoma detection pattern
Glaucoma analysis -optic disk RNFL
Single acquisition for 12mmx6mm Large range of fundus volume images
Thickness analysis and quantitative analysis can be performed on the macular area and optic disc area

Macular detection mode
3D visualization, automatic thickness analysis
Clear stratification, without any loss of detail
Multi-line scanning mode more comprehensive scope